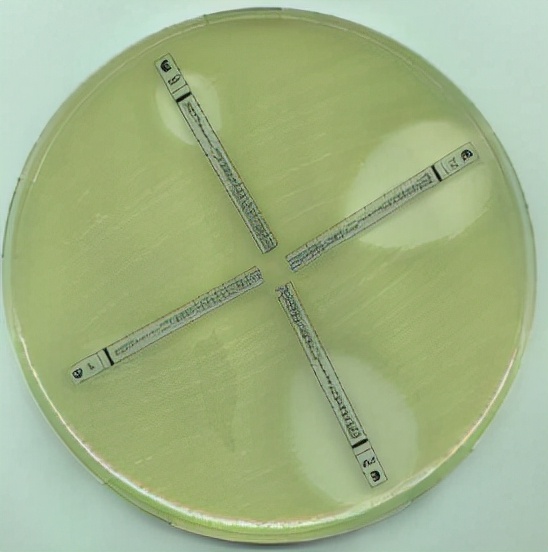
药敏是查什么的,药敏报告是怎么检查

感染性疾病的诊治,一般包括三步,定性、定位、定因。首先确定是否为感染性疾病,其次明确是哪个部位的感染,颅内感染、肺部感染、感染性心内膜炎、肝脓肿、泌尿系感染等等,最后确定病原菌是细菌、病毒、真菌,还是支原体、衣原体、寄生虫等。
什么是药敏试验?
药敏试验是体外抗菌药物敏感性试验的简称。是指在体外测定药物抑菌或杀菌能力的试验。一般 以患者的血液、体液、排泄物为标本,进行细菌分离培养、鉴定及敏感性测定,以达到诊断和治疗的目的。

药敏试验方法有哪些?
1. 纸片扩散法(K-B法):将含有定量抗菌药物的滤纸片贴在已接种了测试菌的琼脂表面上,纸片中的药物在琼脂中扩散,随着扩散距离的增加,抗菌药物的浓度呈对数减少,从而在纸片的周围形成浓度梯度。同时,纸片周围抑菌浓度范围内的菌株不能生长,而抑菌范围外的菌株则可以生长,从而在纸片的周围形成透明的抑菌圈,不同的抑菌药物的抑菌圈直径因受药物在琼脂中扩散速度的影响而可能不同,抑菌圈的大小可以反映受试菌对药物的敏感程度,并与该药物对受试菌的MIC呈负相关。


2. 稀释法(MIC法):以一定浓度的抗菌药物与含有受试菌的培养基进行一系列不同倍数稀释(通常为双倍稀释),培养16-24h后,通过观察细菌生长现象来测得药物对受试菌的最低抑菌浓度(MIC)。

3.抗生素浓度梯度法(E-test法): 将稀释法和扩散法的原理结合起来,直接测定药物对受试菌的MIC。

4.自动仪器药敏检测。
药敏报告中S、R和I指什么?
敏感S(susceptible):分离菌株能被测试药物使用推荐剂量时在感染部位通常可达到的抗菌药物浓度所抑制,即细菌对抗菌药物敏感,使用常规剂量时平均血浓度超过MIC5倍以上,用常规剂量通常有效。中介I(intermediate)是指细菌对抗菌药中度敏感,常规剂量时平均血药浓度等于或略高于MIC,需用高剂量或对体内药物浓缩部位的感染可能有效。耐药R(resistance) :分离菌株不能被测试药物常规剂量可达到的药物浓度所抑制,即细菌对抗菌药耐药,药物对细菌的MIC高于应用常规剂量时的血药浓度,应用常规剂量治疗通常无效。
